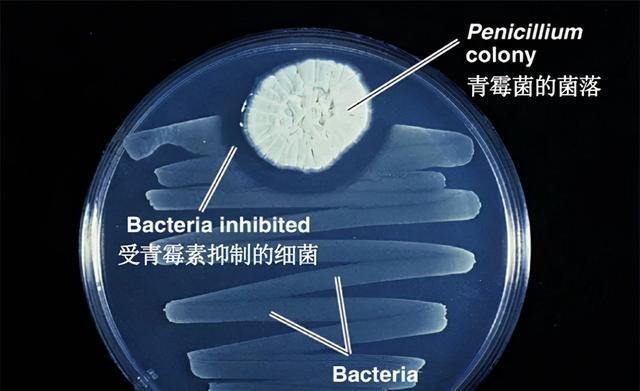
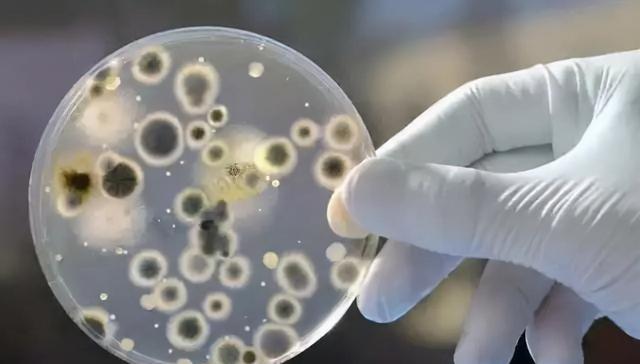

1956年,美国一名科研人员在进行实验时,错误地将1兆欧的电阻器当成了1万兆欧的电阻器,装在了记录器上,结果,记录器电路产生了节奏如同人体心跳的信号。自此,全球十个最伟大的工程学发明之一诞生了…… 威尔逊·格雷特巴赫1919年9月6日出生在纽约州布法罗市。他父亲是英国移民过来的建筑承包商,负责各种建筑项目,母亲则在家操持家务。他在当地公立学校上学,从小对电子设备感兴趣,常拆卸旧收音机,用废品店零件组装简单电路。 青少年时,他在西塞内卡高中读书,课余搭建业余无线电台,与远方爱好者交流信号。1941年二战爆发,他中断大学学习,加入海军当航空首席无线电员,维护飞机通信系统,1945年荣誉退役。 借助退伍军人法案,他进康奈尔大学读电气工程,1950年获学士学位。毕业后在康奈尔航空实验室当助理工程师,1952到1953年参与航空电子研究,设计测试仪器。后来转到布法罗大学任助理教授,1957年拿硕士学位。那时他加入动物行为研究项目,设计设备监测羊和猴子生理信号,如心率和脑波,还和外科医生讨论心脏传导阻滞问题,即电信号无法正常传递导致心律不稳。 威尔逊·格雷特巴赫在1958年组装心音记录装置时,原本需要10千欧电阻,却误读颜色编码,拿了1兆欧的装上。电路通电后,没记录声音,反而产生间隔1秒的1.8毫秒脉冲,像心跳节奏。 他检查发现电阻值错了,高阻值让阻塞振荡器转为脉冲模式。他调整参数,确认这信号能模拟心脏电刺激,适合植入调节心律。花两个月优化设计,用环氧树脂封装组件,测试耐用性。 他和医生威廉·查达克、安德鲁·盖奇合作,1958年5月7日在布法罗退伍军人医院动物实验室测试。他们在狗身上植入装置,心律从不稳转为稳定,监测几小时确认有效。 之后继续改进电池和电极,构建50个原型,在动物身上验证耐久性。1960年4月7日,在医院将装置植入一名77岁男子,他患完全性房室传导阻滞,装置运行平稳,心跳恢复正常。这标志着植入式心脏起搏器首次成功用于人类。 发明推广后,格雷特巴赫与美敦力公司合作10年,生产起搏器。1960年后数千患者受益,他授权专利,推动批量制造。 1970年,他成立自家企业,开发锂碘电池,寿命达10年,取代汞锌电池,成为标准配置。到1980年代,起搏器体积缩小,功能增多,如自动调整速率。 他获325项专利,包括艾滋病研究工具和太阳能独木舟。1991年为庆72岁生日,他驾太阳能独木舟在纽约指湖航行160英里,检查电池性能。 晚年投资植物燃料,支持威斯康星大学麦迪逊分校氦基聚变反应研究,提供资金和设备。他访问学校,分享发明经验。 2011年9月27日,他在家乡威廉斯维尔去世,享年92岁。公司继续运营,生产医疗电池,推动心脏设备进步。他的遗产包括起搏器技术,拯救数百万生命。